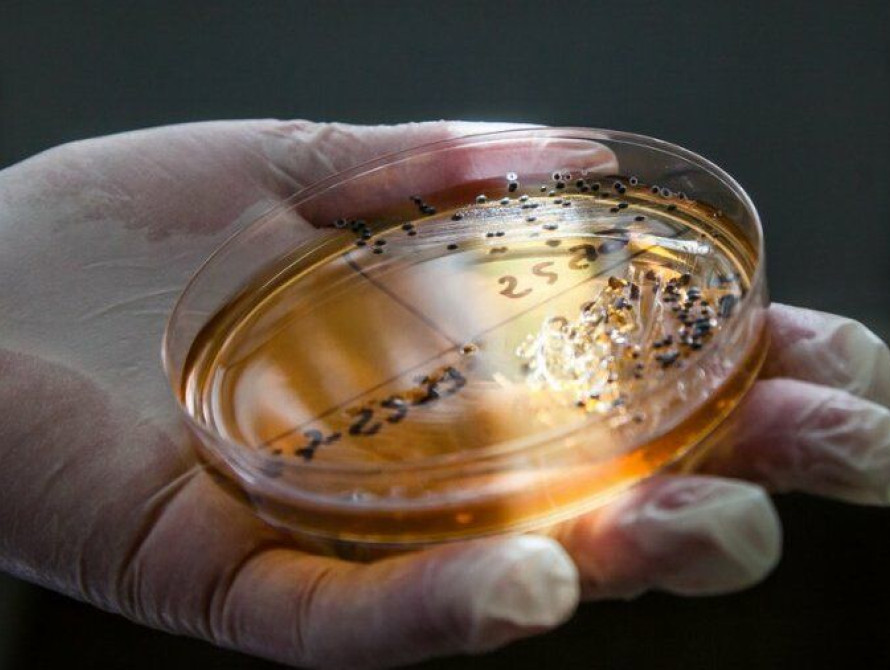

За тиждень у Запоріжжі зафіксували зростання випадків гострих кишкових інфекцій майже на 50%. Загалом зареєстровано понад 122 випадки інфекційних захворювань. Детальніше – «ЗаБор».
З 27 березня по 3 квітня 2026 року на Запоріжжі зафіксували 122 випадки інфекційних захворювань.
Найбільше зросла захворюваність на гострі кишкові інфекції – на 46,4% у порівнянні з попереднім тижнем. Зафіксовано 41 випадок, з яких 63,4% – це діти. Серед ВПО зареєстровано 9 випадків. Також на сальмонельоз захворіла одна дитина. Водночас випадків вірусного гепатиту А та дизентерії не виявлено.
Захворюваність на ГРВІ (включно з COVID-19) залишається нижчою за епідемічний поріг на 44,1% та знизилась на 12,1% у порівнянні з попереднім тижнем. Усього зареєстровано 2347 випадків, понад половина хворих – діти. Випадків COVID-19 за тиждень не зафіксовано.
Також медики виявили 26 випадків грипу (типи А і В). Від початку епідсезону на грип захворіли 746 осіб, понад тисячу людей вакцинувалися.
Окрім цього, 36 мешканців звернулися по медичну допомогу через укуси тварин, ще 6 — через укуси кліщів. Випадків хвороби Лайма за тиждень не зафіксовано.